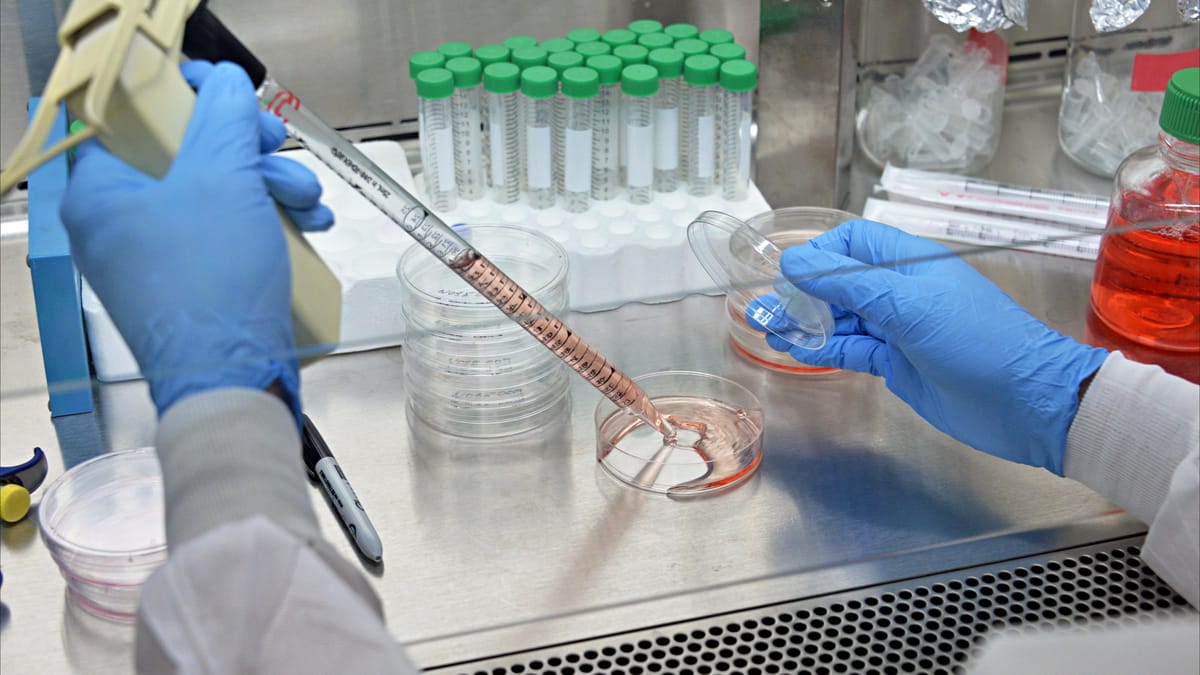
الخلايا السرطانية "تتحد" للبقاء حيّة؟

كشفت دراسة أميركية أن الخلايا السرطانية تتعاون فيما بينها لمواجهة تحديات نقص المغذيات من أجل البقاء على قيد الحياة.
واكتشف فريق بحثي من جامعة نيويورك أنه في حالات نقص الغذاء، تتعاون الخلايا السرطانية عن طريق إفراز نوع من الإنزيمات يحمل اسم CNDP2 حيث يقوم بتكسير المواد البروتينية إلى أحماض أمينية تتقاسمها هذه الخلايا. وأكد الباحثون أن هذا الاكتشاف يفسح المجال أمام ابتكار وسائل جديدة لعلاج الأورام عن طريق منع عمل هذا الإنزيم أو التخلص من الشفرة الجينية الخاصة به من أجل إبطاء نمو الأورام داخل الجسم.
ويقول الباحث كارلوس كارمونا فونتين، الباحث بجامعة نيويوك ورئيس فريق الدراسة: "لقد اكتشفنا التفاعلات التعاونية بين خلايا السرطان التي تسمح لها بالبقاء والانتشار"، مضيفا في تصريحات للموقع الإلكتروني "سايتيك ديلي" المتخصص في الابحاث العلمية، أن "فهم الآليات التي تستغلها الخلايا السرطانية للاستمرار قد يساعد في التوصل إلى علاجات جديدة في المستقبل".
وكان العلماء يعتقدون من قبل أن الخلايا السرطانية تتنافس على المغذيات والموارد الأخرى داخل الجسم، وأن الأورام تزداد شراسة بمرور الوقت لأن الخلايا الأقوى هي التي تهيمن على موارد الجسم.
ولكن الباحثين توصلوا إلى أن الخلايا الحية بشكل عام تتعاون فيما بينها في الظروف الصعبة. وفي إطار الدراسة التي نشرتها الدورية العلمية Nature، فحص الباحثون تطور نمو أنواع مختلفة من الأورام باستخدام مجهر روبوتي وبرنامج متخصص لتحليل الصور عن طريق إجراء عمليات إحصاء لملايين الخلايا السرطانية تحت مئات الظروف المختلفة، مما سمح للباحثين بدراسة معدلات كثافة التجمعات السرطانية مع تعديل نسبة المغذيات المتوافرة في كل مرة.
وذكر الباحث كارلوس فونتين أن "الأمر المدهش أننا لاحظنا أن تقليل الأحماض الأمينية يعود بالفائدة على التجمعات السرطانية الأكبر، مما يشير إلى وجود عملية تعاونية بين التجمعات السرطانية التي تحتوي على أعداد أكبر من الخلايا، وهو ما يدل على وجود تعاون حقيقي بين خلايا الأورام.